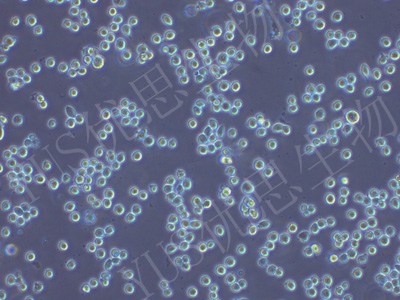

产品中心
产品中心
-

ACT-1 人甲状腺癌细胞(未分化)(STR鉴定)
货号:YLH032规格: 1*10^6 -

HUTU-80 人十二脂肠腺癌(STR鉴定)
货号:YLH036规格: 1*10^6 -

HEK-293 人胚肾细胞(STR鉴定)
货号:YLH037规格: 1*10^6 -

MDA-MB-361 人乳腺癌细胞(STR鉴定)
货号:YLH038规格: 1*10^6 -

L-02 人正常肝细胞(STR鉴定)
货号:YLH039规格: 1*10^6 -

HSC-3 人口腔鳞状细胞癌细胞(STR鉴定)
货号:YLH040规格: 1*10^6 -

COC1 人卵巢癌细胞(STR鉴定)
货号:YLH041规格: 1*10^6 -

Bxpc-3 人原位胰腺腺癌细胞(STR鉴定)
货号:YLH042规格: 1*10^6 -

TJ905 人胶质瘤细胞(STR鉴定)
货号:YLH043规格: 1*10^6 -

MKN-45 人胃癌细胞(STR鉴定)
货号:YLH044规格: 1*10^6 -
HEL 人红白细胞白血病细胞(STR鉴定)
货号:YLH045规格: 1*10^6 -

U-937 人组织细胞淋巴瘤细胞(STR鉴定)
货号:YLH047规格: 1*10^6
在线咨询
Online consultation

关注微信公众号


